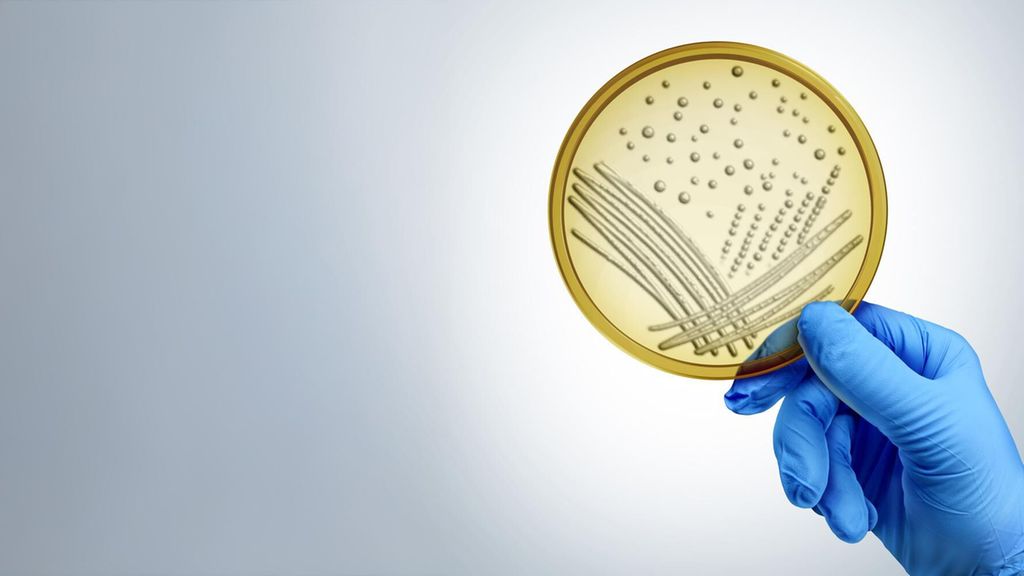

Biomarqueurs hématologiques des infections – qu’est-ce qui est pertinent etdans quel cas?
Auteure:
Prof. univ. Dre méd. Cornelia Lass-Flörl
Institut für Hygiene und Medizinische Mikrobiologie
Medizinische Universität Innsbruck
E-mail: cornelia.lass-floerl@i-med.ac.at
Le dosage de différents biomarqueurs joue un rôle important dans le dépistage des infections fongiques invasives. L’évaluation d’un biomarqueur positif en cas d’infections fongiques dépend de la probabilité clinique pré-test, de la spécificité/sensibilité du test, du tableau clinique et de la dynamique des valeurs du biomarqueur. Un résultat positif doit toujours être interprété avec d’autres résultats afin de diagnostiquer ou d’exclure avec certitude une infection fongique invasive.
Keypoints
-
Selon l’approche multimodale, un biomarqueur positif ne doit jamais être évalué seul. Au lieu de cela, il faut combiner les symptômes cliniques et les facteurs de risque (p.ex. fièvre chez les patient·es neutropéniques), l’imagerie (p.ex. TDM thoracique en cas de suspicion d’aspergillose pulmonaire) ainsi que les méthodes mycologiques (p.ex. culture et microscopie).
-
La combinaison de biomarqueurs peut constituer un outil complémentaire pertinent.
-
Les résultats des biomarqueurs ne doivent pas être automatiquement mis sur le même plan que ceux d’une culture ou d’une microscopie positive; il convient d’attirer l’attention sur leur valeur différente.
Les infections fongiques invasives sont une cause importante de morbidité et de mortalité chez les patient·es immunodéprimé·es.1 Les agents pathogènes les plus importants et les plus fréquents en Europe sont les espèces Aspergillus et Candida. Cependant, d’autres représentants tels que les espèces Mucorales, Trichosporon et Fusarium sont de plus en plus souvent détectés.
Alors que les infections fongiques superficielles sont souvent diagnostiquées au premier coup d’œil, il est difficile de poser un diagnostic avec certitude pour les infections fongiques invasives. Cela est uniquement possible en combinant l’examen clinique, l’imagerie radiologique et les méthodes de détection microbiologiques2 (p.ex. microscopie, culture ainsi qu’approches immunologiques et de biologie moléculaire). L’utilisation de biomarqueurs diagnostiques, dont l’objectif est d’identifier les microbes ou de clarifier le statut d’une réponse immunitaire, en fait partie intégrante. Les infections peuvent ainsi être diagnostiquées de manière indirecte. Les procédures peuvent être spécifiques à l’agent pathogène.
La différence entre les biomarqueurs diagnostiques, pronostiques et thérapeutiques réside dans leur fonction ainsi que leur objectif dans la pratique médicale.3 Le Tableau 1 fournit un aperçu des biomarqueurs disponibles sur le marché pour les agents pathogènes fongiques.
Les différents biomarqueurs fongiques
Galactomannane
Le galactomannane (GM) est un composant de la paroi cellulaire d’Aspergillus fumigatus et sert au diagnostic de l’aspergillose invasive. Ce test est souvent appelé «test de l’antigène Aspergillus».4 La présence du GM est corrélée à la croissance invasive d’Aspergillus, des réactions croisées avec d’autres champignons ont été décrites. Le profil cinétique du GM dans le sérum est complexe et dépend de plusieurs facteurs (p.ex. présence et fonction des neutrophiles) ainsi que de l’exposition à des antifongiques agissant contre les espèces Aspergillus. Cela explique, entre autres, les performances variables duGM dans différents groupes de patient·es.2
1,3-β-D-glucane
Le 1,3-β-D-glucane (BDG) est un composant important de la paroi cellulaire de nombreux champignons pathogènes pour l’homme, c’est pourquoi il peut être détecté dans le sérum pour de nombreuses infections fongiques (Candida, Aspergillus, Pneumocystis). On parle de marqueur panfongique. En cas d’infection à Mucorales et à Cryptococcus, le test est généralement négatif.2
Antigène cryptococcique
L’antigène cryptococcique (CrAg) est un biomarqueur diagnostique établi qui est plus sensible que la culture; le test à flux latéral (CrAg LFA) est le plus sensible. Les titres séquentiels de CrAg dans le LCR ne doivent pas être utilisés pour surveiller la réponse au traitement.2
Avantages et inconvénients des méthodes de biologie moléculaire
De nombreuses méthodes de biologie moléculaire font partie des test diagnostiques de laboratoire, mais il convient de toujours les effectuer en combinaison avec une microscopie et une culture.
Les avantages des tests moléculaires comprennent généralement une sensibilité et une spécificité élevées, l’utilisation d’échantillons non invasifs, la détection de mutations associées à la résistance et un temps de traitement rapide.3,4 Les inconvénients se traduisent par des coûts élevés ainsi que des difficultés à distinguer l’infection de la colonisation dans les échantillons non stériles.
Dans la pratique, on distingue les cibles panfongiques à large spectre et les cibles spécifiques à un agent pathogène. Les espèces Candida sont couvertes par certains tests de dépistage de la septicémie («panel testing») disponibles sur le marché, mais les données ne sont pas tout à fait claires. Pour l’espèce Aspergillus, les études cliniques démontrent clairement le bénéfice de l’utilisation de méthodes diagnostiques de biologie moléculaire.4
Séquençage métagénomique
Un intérêt croissant est porté au séquençage métagénomique (plateforme NGS, p.ex. test de Karius), qui détecte l’ADN libre circulant (cfDNA) dans le plasma afin d’identifier plus de 1250 agents pathogènes humains, y compris des bactéries, des champignons et des virus à ADN.4 Le terme «test agnostique» est utilisé ici, car aucune information ciblée sur des agents pathogènes spécifiques n’est nécessaire.
Le séquençage du cfDNA a été étudié dans une étude rétrospective portant sur 114 patient·es ayant reçu une greffe de cellules souches hématopoïétiques et ayant développé une pneumonie fongique (n=75). Des échantillons sériques prélevés dans les 14 jours suivant le diagnostic d’infection invasive par des moisissures ont été analysés. Le séquençage du cfDNA a identifié des moisissures chez 38 patient·es (sensibilité: 51%; IC à 95%: 39–62%).
Lorsque les tests ont été limités aux échantillons prélevés dans les trois jours suivant le diagnostic d’une infection invasive par des moisissures, la sensibilité s’est améliorée jusqu’à atteindre 61%. La spécificité était de 95% (IC à 95%: 82–100%). Le rôle du séquençage du cfDNA dans le plasma dans le diagnostic des pneumonies fongiques chez les patient·es immunodéprimé·es pour lesquel·les les tests diagnostiques microbiologiques de routine, tels que la culture fongique par LBA, le GM et la PCR, sont négatifs, reste incertain.4
L’utilisation de biomarqueurs est un outil complémentaire important du diagnostic conventionnel et peut confirmer ou infirmer la suspicion de mycose. La confirmation d’une infection fongique passe par une microscopie ou une culture à partir d’une région corporelle stérile (p.ex. biopsie) positive. Tous les autres résultats positifs indiquent la présence probable ou possible d’une infection.
Tab.2: Diagnostic des biomarqueurs dans les infections fongiques invasives (modifié selon Maertens J et al.,1 Póvoa P et al.,3 Lass-Flörl C4)
Les biomarqueurs dans la pratique quotidienne: avantages et inconvénients
Toute procédure diagnostique comporte un risque résiduel de résultats erronés, qui peuvent être aussi bien des faux positifs que des faux négatifs.5 Lors du choix d’un système de test, on ne tient donc pas seulement compte des coûts, mais aussi du «taux d’erreur» attendu.
Pour évaluer les tests de laboratoire, la validité des tests (capacité à faire la distinction entre la présence et l’absence d’une maladie) est essentielle. La validité du test comprend deux composantes importantes: la sensibilité (capacité à détecter une maladie) et la spécificité (capacité à exclure une maladie). Les sensibilité et spécificité élevées des tests de laboratoire existants, associées aux coûts comparativement faibles des tests individuels, incitent actuellement à une vaste utilisation non critique.5
Il est donc important de tenir compte des points suivants lors de l’utilisation de tests diagnostiques:
-
La sensibilité et la spécificité sont des «propriétés spécifiques au test» sur lesquelles l’examinateur·rice ne peut pas influer activement. Ceci est valable à condition que les tests soient effectués et interprétés correctement, y compris lors des phases pré- et post-analytiques.5,6
-
En revanche, la valeur informative d’un résultat de test positif, c’est-à-dire la valeur prédictive positive (VPP), dépend fortement de la prévalence de la maladie dans le groupe examiné – et les médecins (examinateurs·rices) peuvent influencer cette prévalence. Les valeurs prédictives (probabilité) dépendent de la prévalence (fréquence) de la maladie.5,6
-
La valeur prédictive positive d’un résultat de test de laboratoire est directement liée à la prévalence de la maladie dans le groupe examiné.
-
La valeur informative clinique des résultats des tests de laboratoire dépend donc d’une indication claire.
-
Les résultats de tests non indiqués sont inutilisables sur le plan clinique sans une base de données solide sur la prévalence de la maladie et les tests ne doivent donc pas être effectués.
-
En principe, il faut uniquement effectuer des tests lorsqu’ils sont indiqués, car ce n’est qu’alors qu’un résultat de test est utilisable sur le plan clinique.
Littérature:
1 Maertens J et al.: Breaking the mould: challenging the status quo of clinical trial response definitions for invasive fungal diseases – a debate. J Antimicrob Chemother 2024; 79(8): 1786-93 2 Lass-Flörl C et al.: Serology anno 2021 – fungal infections: from invasive to chronic. Clin Microbiol Infect 2021; 27(9): 1230-41 3 Póvoa P et al.: How to use biomarkers of infection or sepsis at the bedside: guide to clinicians. Intensive Care Med 2023; 49(2): 142-53 4 Lass-Flörl C: Diagnostic approaches for invasive mycoses: what’s hot? Dtsch Med Wochenschr 2024; 149(10): 551-9 5 Suling A, Großhennig A: Statistische Problemstellen in Publikationen von klinischen Studien erkennen – eine Lesehilfe. Teil 33 der Serie zur Bewertung wissenschaftlicher Publikationen. Dtsch Ärztebl Int 2024; 121: 634-8 6 Lass-Flörl C et al.: Invasive candidiasis. Nat Rev Dis Primers 2024; 10(1): 20
Das könnte Sie auch interessieren:
État des lieux sur l’asthme: AIR, MART et médicaments biologiques
Les SABA, longtemps utilisés dans le traitement de l’asthme bronchique, sont aujourd’hui largement obsolètes et se sont révélés moins efficaces qu’un traitement combiné d’entretien et de ...
Souvent, une antibioprophylaxie n’est pas nécessaire
La question de savoir si une antibioprophylaxie est nécessaire lors des interventions endoscopiques, en particulier au niveau du tractus gastro-intestinal, fait toujours l’objet de ...
Médicaments spécifiques à l’ATTR-CM: revue systématique et méta-analyse
La présente méta-analyse1 est le premier travail qui harmonise les études cliniques randomisées contrôlées sur le traitement spécifique à l’amylose dans l’amylose à transthyrétine avec ...




